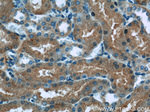
HACL1 Antibody in Immunohistochemistry (Paraffin) (IHC (P))

Search
Proteintech
HACL1 Polyclonal Antibody
{{$productOrderCtrl.translations['antibody.pdp.commerceCard.promotion.promotions']}}
{{$productOrderCtrl.translations['antibody.pdp.commerceCard.promotion.viewpromo']}}
{{$productOrderCtrl.translations['antibody.pdp.commerceCard.promotion.promocode']}}: {{promo.promoCode}} {{promo.promoTitle}} {{promo.promoDescription}}. {{$productOrderCtrl.translations['antibody.pdp.commerceCard.promotion.learnmore']}}
产品信息
15519-1-AP
种属反应
宿主/亚型
分类
类型
抗原
偶联物
形式
浓度
规格
纯化类型
保存液
内含物
保存条件
运输条件
产品详细信息
Immunogen sequence: AHAEESIKK LVEQYKLPFL PTPMGKGVVP DNHPYCVGAA RSRALQFADV IVLFGARLNW ILHFGLPPRY QPDVKFIQVD ICAEELGNNV KPAVTLLGNI HAVTKQLLEE LDKTPWQYPP ESKWWKTLRE KMKSNEAASK ELASKKSLPM NYYTVFYHVQ EQLPRDCFVV SEGANTMDIG RTVLQNYLPR HRLDAGTFGT MGVGLGFAIA AAVVAKDRSP GQWIICVEGD SAFGFSGMEV ETICRYNLPI ILLVVNNNGI YQGFDTDTWK EMLKFQDATA VVPPMCLLPN SHYEQVMTAF GGKGYFVQTP EELQKSLRQS LADTTKPSLI NIM (227-558 aa encoded by BC001627)
靶标信息
HACL1 gene ontology annotations related to this gene include lyase activity; magnesium ion binding; thiamine pyrophosphate binding.
仅用于科研。不用于诊断过程。未经明确授权不得转售。
篇参考文献 (0)
生物信息学
蛋白别名: 1600020H07Rik; 2-HPCL; 2-hydroxyacyl-CoA lyase 1; 2-hydroxyphytanol-CoA lyase; 2-hydroxyphytanoyl-CoA lyase; 2-hydroxyphytanoyl-Coenzyme A lyase; Phytanoyl-CoA 2-hydroxylase 2; phytanoyl-CoA hydroxylase 2; phytanoyl-Coenzyme A 2-hydroxylase 2; unnamed protein product
基因别名: 1600020H07Rik; 2-HPCL; 2hpcl; HACL1; HPCL; HPCL2; HSPC279; PHYH2
UniProt ID: (Human) Q9UJ83, (Rat) Q8CHM7, (Mouse) Q9QXE0
Entrez Gene ID: (Human) 26061, (Rat) 85255, (Mouse) 56794